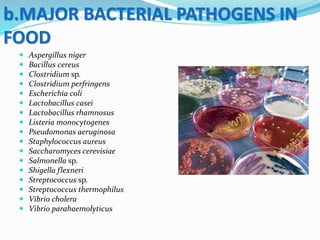
 Aspergillus niger
 Bacillus cereus
 Clostridium sp.
 Clostridium perfringens
 Escherichia coli
 Lactobacillus casei
 Lactobacillus rhamnosus
 Listeria monocytogenes
 Pseudomonas aeruginosa
 Staphylococcus aureus
 Saccharomyces cerevisiae
 Salmonella sp.
 Shigella flexneri
 Streptococcus sp.
 Streptococcus thermophilus
 Vibrio cholera
 Vibrio parahaemolyticus
b.MAJOR BACTERIAL PATHOGENS IN
FOOD

This document discusses food safety and testing. It begins by defining food and categories of food poisoning such as natural, chemical, bacterial and viral. It then discusses important pillars of the national food control system such as legislation, inspection, testing and enforcement. Major sections cover food safety issues, categories of foodborne illness, compliance, risks in hotels/restaurants, and analysis techniques for chemicals, microbiological contaminants, residues and nutrition in various food products. A wide range of tests are described to ensure safety of foods like milk, cereals, oils and water according to regulatory standards.